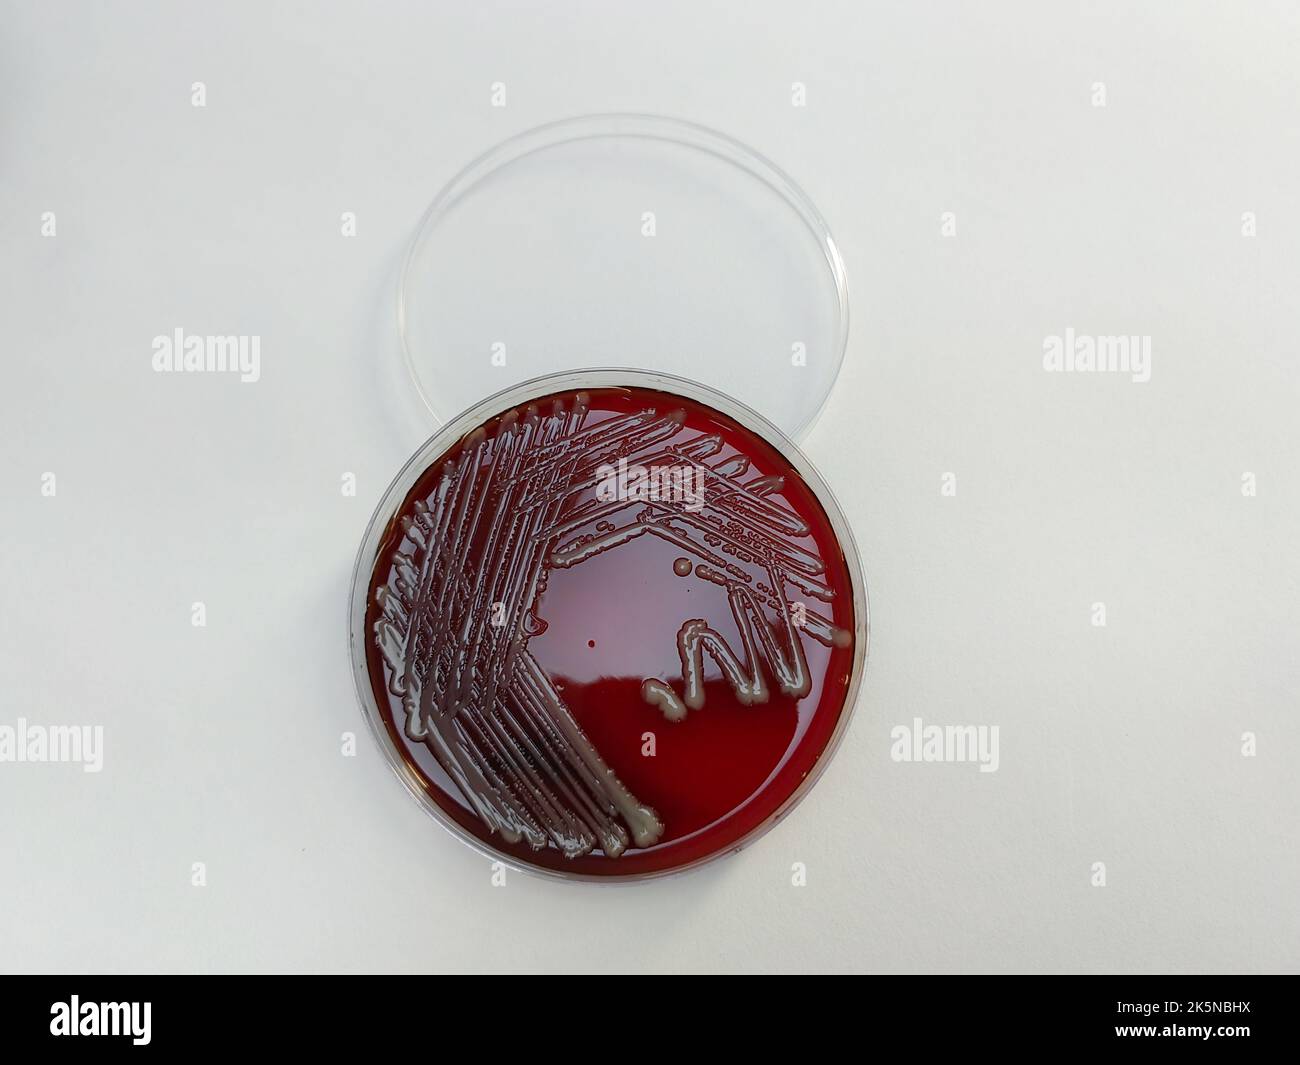
Une bactérie SARM staphylococcus aureus affichée sur une plaque de gélose au sang sur une surface blanche Banque D'Images

Une bactérie SARM staphylococcus aureus affichée sur une plaque de gélose au sang sur une surface blanche
RFID:ID de l’image:2K5NBHX
Détails de l'image
Contributeur:
Wirestock, Inc.ID de l’image:
2K5NBHXTaille du fichier:
144 MB (1,6 MB Téléchargement compressé)Autorisations:
Modèle - non | Propriété - nonUne autorisation est-elle nécessaire?Dimensions:
8192 x 6144 px | 69,4 x 52 cm | 27,3 x 20,5 inches | 300dpiPhotographe:
WireStock